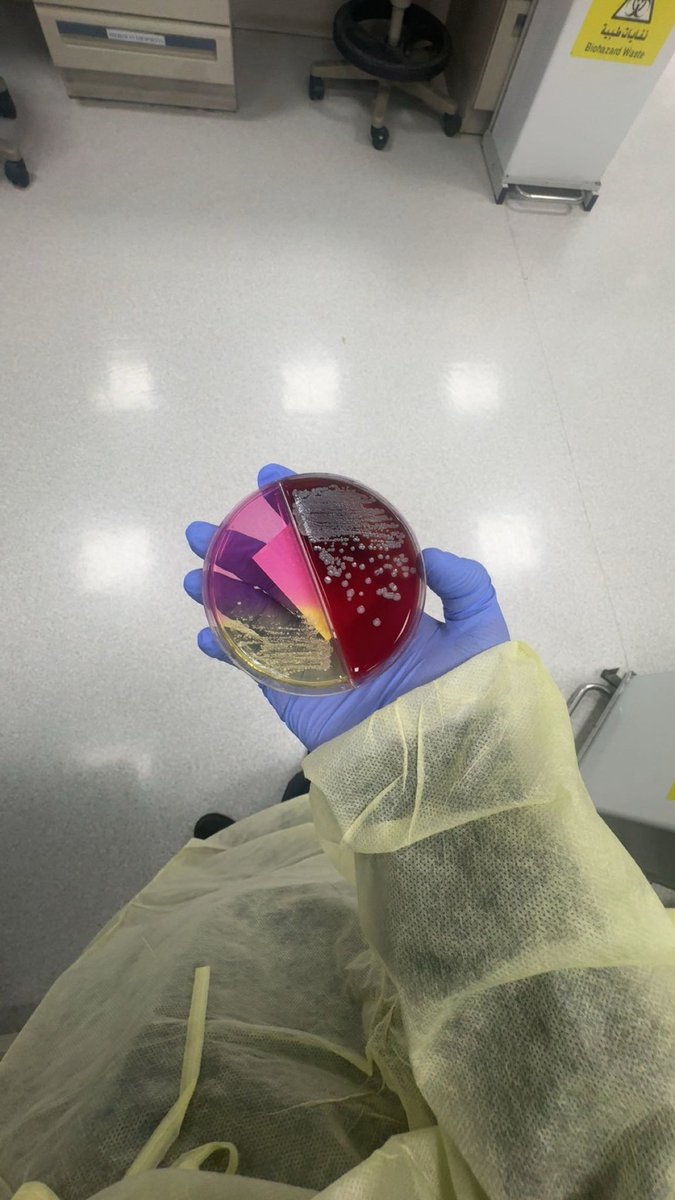
‎نُ ✍🏻 tweet media

Sabitlenmiş Tweet
نُ ✍🏻
1.4K posts


نُ ✍🏻
@NNNF29
Laboratory internship at @ksumedicalcity 🧬🧪|#KSU| |#CLS443| 🤍 Part of @CLS_club💜
Riyadh Katılım Nisan 2014
117 Takip Edilen263 Takipçiler

الهلال ديونه 0 مقابل أندية ديونها مليارية
الهلال ميزانيته المعلنة رسميا سنتين متتالية تتجاوز مليار مقابل أندية إما لم تعلن ميزانيتها أو ميزانيها بالسالب ولا تشكل 50٪ من هذا الرقم
الهلال يملك داعم سمو الأمير الوليد بن طلال حفظه الله تكفل بصفقات كثيرة وهذا شيء معلن ماهو سر ، مقابل أندية ما تملك داعم واحد
كل ما سبق وتلاقي شخص مسكين محتقن مؤدلج يطالب بمساواة ويردد نظريات مؤامرة لا تعبر الا عن جهل ونظرة قاصرة وإنتقائية
إستحواذ الصندوق قلّص مسافة بين الهلال والبقية عمرها ما كانت راح تتقلص ، النصر الاتحاد الاهلي حظوا بصفقات نوعية وهيكلة إدارية وحوكمة لم تقترب من جودتها أنديتهم طوال تاريخها ، دائما كان الهلال أقرب نموذج بين الجميع للحوكمة والأنجح رياضيا وماليا
العربية